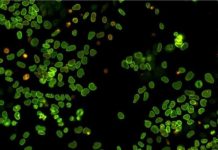
Research: The birth and death of proteins in a single cell —

Research: 3D images of a skin molecule involved in temperature sensation could lead to...
Columbia University biomedical researchers have captured close-up views of TRPV3, a skin-cell ion channel that plays important roles in sensing temperature, itch, and...
Research: Shape-shifting material can morph, reverse itself using heat, light —
A new material developed by University of Colorado Boulder engineers can transform into complex, pre-programmed shapes via light and temperature stimuli, allowing a...
Research: The birth and death of proteins in a single cell —
The amount of proteins inside cells fluctuate over time and this affects various functions of the cells themselves. Cells are constantly synthesizing and...
Research: how our brain responds to unexpected situations —
Scientists have demonstrated that the motor cortex is necessary for the execution of corrective movements in response to unexpected changes of sensory input...
Research: New channel-gating mechanism discovered —
When computational biophysicist Jianhan Chen at the University of Massachusetts Amherst and colleagues cracked the secret of how cells regulate Big Potassium (BK)...
Research: Researchers apply social and ecological theory to understand human/black bear conflicts in Colorado...
Wildlife Conservation Society. "Human/wildlife conflict: Social and ecological theory: Researchers apply social and ecological theory to understand human/black bear...
Research: Reasons for massive fires in south-central Chile —
A Montana State University-led team has discovered several reasons why massive fires continue to burn through south-central Chile.
Besides low humidity, high winds and...
Research: Important implications for shark protection from longline fishing activities —
A new analysis shows that the habitats of three shark species (great hammerhead, tiger, and bull sharks) are relatively well protected from longline...
Research: In parasitic worm infection both the host and the worm produce cannabis-like molecules...
Like mammals, parasitic worms have an endocannabinoid system that may help the worm and the hosts it infects survive by reducing pain and...
Research: Martens recolonized Isle Royale in the ’90s, showing island’s dynamism —
After decades of trapping, the last known American marten was spotted on Isle Royale in 1917. Fifty years later, in 1966, the National...
Top News
Hey ISIS, You Suck: Local Muslims Post Anti-ISIS Billboard
A new billboard on Manchester Road in Missouri reads, "HEY ISIS, YOU SUCK!!! From: #ActualMuslims."
A group of Muslim-Americans have put up a blunt billboard...